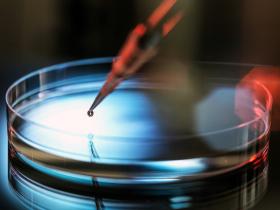

Medicina regenerativa en dermatología
Investigadora de la Clínica Mayo busca nuevas curas para problemas de la piel relacionados con la edad.
La medicina regenerativa es un campo naciente que busca reparar, reemplazar o restaurar células, tejidos y órganos dañados. En la Clínica Mayo de Rochester en Estados Unidos, la dermatóloga Saranya Wyles investiga nuevas curas para problemas de la piel relacionados con la edad como arrugas, manchas, caída de cabello y fragilidad cutánea.
“La dermatología tiene una conexión natural con la medicina regenerativa, porque la piel es el órgano de mayor tamaño que se regenera en el cuerpo. A través de ella es posible ver afecciones relacionadas con la edad y enfermedades inflamatorias complejas que necesitan tratamientos que van más allá de lo que actualmente disponemos”, comenta.
Los estudios de la doctora Wyles se concentran en las células senescentes del envejecimiento y de las enfermedades de la piel que secretan proteínas y sustancias químicas nocivas que se convierten en algo semejante a una “tierra tóxica”, que está en un solo sitio o en todas partes y perturba la función de las células madre.
El propósito de su laboratorio es “entender la senescencia celular de la piel y su función en los trastornos de esta, especialmente en la recuperación de las heridas y en la fibrosis o cicatrización. Utilizo senolíticos en modelos preclínicos para investigar si pueden sanar mejor las heridas”.
La apariencia de la piel es importante para las personas. “Si pudiésemos descubrir una forma de darles una más tersa y sana, no solamente favoreceríamos la autoestima, sino también mejoraríamos su calidad de vida”.
Dentro de sus ensayos clínicos examina el empleo de exosomas regenerativos “que envían mensajes de rejuvenecimiento a fin de abordar la senescencia y el envejecimiento de la piel. Nuestro objetivo en el Centro para Medicina Regenerativa es integrar nuevas bioterapias a la atención clínica de los pacientes para ofrecer alternativas de cura a la práctica médica”.